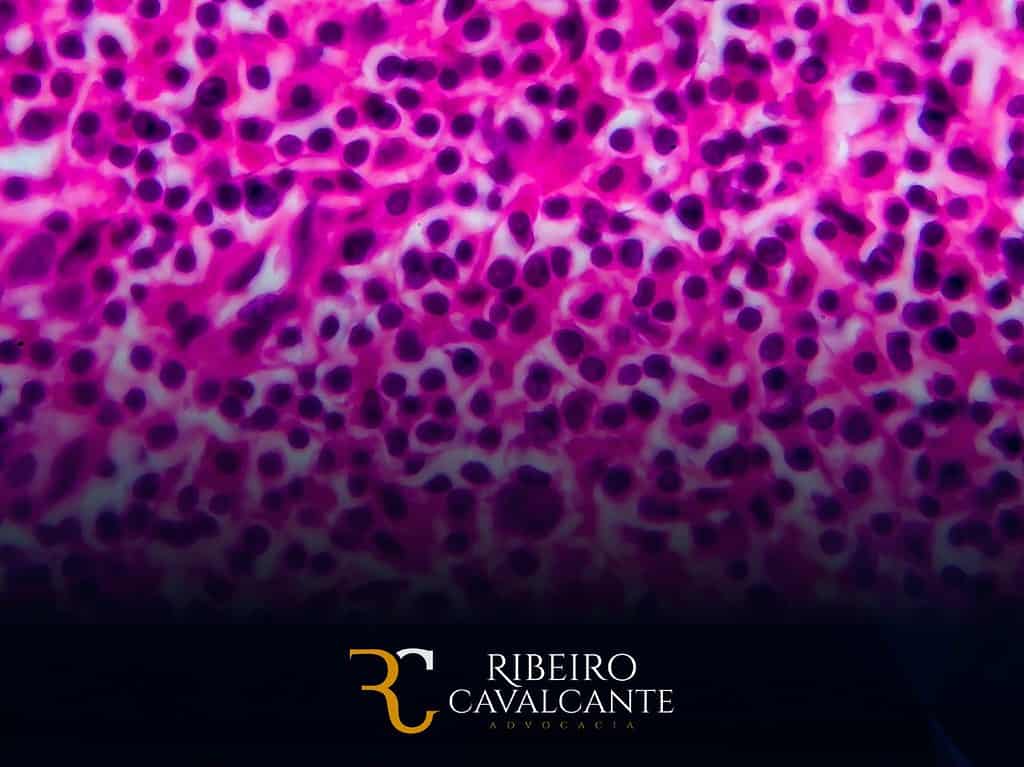
Linfoma de Hodgkin e o Benefício de Prestação Continuada (BPC-LOAS) em 2024

O linfoma de Hodgkin é um tipo de câncer que afeta o sistema linfático, responsável pela defesa do organismo. Ele é caracterizado pela presença de células malignas chamadas de células de Reed-Sternberg.
O que é linfoma de Hodgkin?
O linfoma de Hodgkin pode se manifestar de diferentes formas, mas geralmente apresenta os seguintes sintomas:
- Febre
- Suores noturnos
- Perda de peso sem causa aparente
- Fadiga
- Inchaço nos gânglios linfáticos
Câncer com duração de 2 anos ou mais
Para que um câncer seja considerado incapacitante para fins de concessão do BPC-LOAS, é necessário que ele tenha duração de 2 anos ou mais. No caso do linfoma de Hodgkin, esse requisito é geralmente atendido, pois o tratamento geralmente dura esse período.
Como o linfoma de Hodgkin impede a própria manutenção ou de tê-la provida por sua família
O linfoma de Hodgkin pode causar diversos problemas que podem dificultar a própria manutenção ou de tê-la provida por sua família. Alguns desses problemas incluem:
- Cansaço extremo, que pode dificultar o desempenho de atividades cotidianas;
- Perda de peso, que pode causar desnutrição;
- Fadiga, que pode dificultar o trabalho ou os estudos;
- Inchaço nos gânglios linfáticos, que pode causar dor e desconforto;
- Tratamentos agressivos, que podem causar efeitos colaterais como náuseas, vômitos, diarreia e queda de cabelo.
Os requisitos para concessão do BPC-LOAS:

Os principais requisitos para a concessão do BPC-LOAS incluem:
- Renda familiar per capita: A renda familiar per capita deve ser inferior a 1/4 do salário mínimo vigente. Isso significa que a soma dos rendimentos de todos os membros da família, dividida pelo número de pessoas que compõem a família, não pode ultrapassar esse limite.
- Deficiência ou idade avançada: O beneficiário deve ser pessoa com deficiência, cuja incapacidade seja permanente para a vida independente e para o trabalho, ou idoso com idade igual ou superior a 65 anos.
- Cadastro único: É necessário estar cadastrado no Cadastro Único para Programas Sociais do Governo Federal (CadÚnico). Esse cadastro é uma base de dados que reúne informações sobre as famílias em situação de vulnerabilidade social.
- Avaliação social e médica: Além de preencher os critérios de renda e enquadramento na deficiência ou idade, o requerente passa por avaliação social e médica realizada por profissionais designados pelo Instituto Nacional do Seguro Social (INSS).
É importante ressaltar que o BPC-LOAS é um benefício assistencial, não sendo necessário ter contribuído para o INSS para ter direito a ele. A concessão desse benefício visa assegurar uma renda mínima para aqueles que não têm condições de se manterem de forma digna, considerando as limitações impostas pela idade avançada ou pela deficiência.
O BPC-LOAS é um benefício individual, não vitalício e intransferível. Ele é concedido por prazo indeterminado, mas pode ser suspenso ou cancelado caso o beneficiário deixe de cumprir os requisitos necessários.
Para solicitar o BPC-LOAS, é necessário comparecer a uma agência do INSS ou solicitar o benefício pela internet, no site do INSS. O processo de solicitação é gratuito e não é necessário ter advogado. Todavia, a assistência de um advogado vai te garantir maior probabilidade de ter um caso de sucesso.
O BPC-LOAS é um importante instrumento de proteção social que garante um salário-mínimo aos idosos e pessoas com deficiência que se encontram em situação de vulnerabilidade social.
Exames e documentos necessários para a solicitação do benefício de prestação continuada
Para solicitar o BPC-LOAS, é necessário apresentar os seguintes documentos:
Fale agora com um advogado especialista
Falar com Advogado no WhatsApp- Requerimento do benefício;
- Certidão de nascimento ou casamento;
- CPF;
- Comprovante de residência;
- Renda familiar per capita inferior a 1/4 (um quarto) do salário mínimo vigente;
- Laudo médico que ateste a deficiência.
O laudo médico deve ser emitido por profissional da área da saúde com formação específica para o diagnóstico de linfoma de Hodgkin. O laudo deve conter informações sobre o tipo de linfoma de Hodgkin, o grau de comprometimento e as limitações que a deficiência causa à pessoa.
Conclusão
Pessoas com linfoma de Hodgkin podem ter direito ao benefício de prestação continuada (BPC-LOAS), desde que preencham os requisitos necessários. A Ribeiro Cavalcante Advocacia é uma empresa especializada em direito previdenciário e pode ajudar você a entender seus direitos e a solicitar o benefício de forma adequada.
Entre em contato conosco para saber mais sobre como podemos ajudá-lo.
A Ribeiro Cavalcante Advocacia é referência em assistência jurídica especializada na obtenção de benefícios previdenciários, com destaque para o BPC-LOAS (Benefício de Prestação Continuada – Lei Orgânica da Assistência Social). Nosso dedicado setor de previdenciário conta com profissionais altamente qualificados, incluindo ex-funcionários do INSS, proporcionando mais de 10 anos de experiência na área.


Entendemos as intricadas complexidades que envolvem a concessão de benefícios previdenciários, incluindo as regras e regulamentos que norteiam esse processo. Esse conhecimento aprofundado nos permite oferecer orientação jurídica especializada aos nossos clientes, bem como a capacidade de identificar e abordar questões legais que possam influenciar o resultado de seus pedidos.
Nossa abordagem inicia-se com uma análise minuciosa do caso e da documentação existente, visando identificar os requisitos necessários para a concessão do BPC-LOAS, especialmente nos casos em que o benefício foi indeferido administrativamente. Com expertise consolidada, auxiliamos os clientes na apresentação persuasiva de suas alegações ao INSS, buscando assegurar que todas as nuances do caso sejam consideradas.
Desenvolvemos estratégias de defesa jurídica personalizadas para cada situação, garantindo que as alegações sejam apresentadas de forma clara, completa e convincente. A nossa equipe está empenhada em superar os desafios específicos de cada caso, oferecendo um suporte jurídico robusto que visa a rápida e eficaz obtenção do auxílio-doença indeferido administrativamente.
Com um histórico comprovado de sucesso na obtenção de benefícios previdenciários, incluindo o BPC-LOAS, estamos confiantes de que podemos ajudar nossos clientes a enfrentar esse desafio de maneira assertiva. Conte conosco para obter assistência jurídica de alta qualidade e alcançar resultados positivos em suas demandas previdenciárias.

